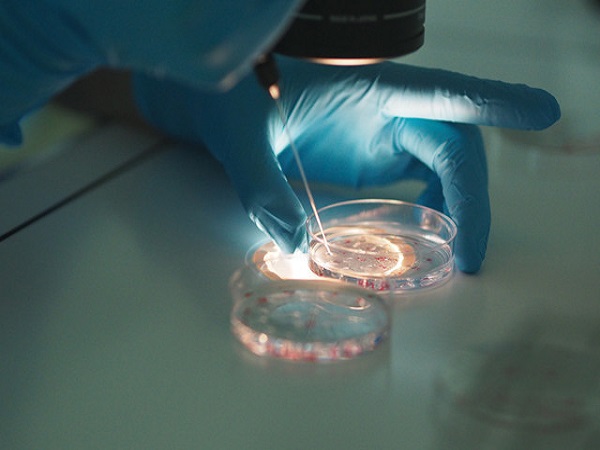

试管可以放两个胚胎的条件汇总,年龄满足要求是重要前提
- 试管婴儿经验
- 2023-04-08 09:27
我们都知道,试管婴儿能够帮助各种原因导致不孕不育的家庭实现生育的愿望。很多人都说试管更容易怀上双胞胎,相较于自然受孕确实如此,这是因为试管会根据女性的身体状况决定移植胚胎的数量,一般会移植1-2枚胚胎,进而提高了多胎妊娠几率。但是需要知道的是,并不是所有的患者都可以放两个胚胎的,女性的年龄、宫腔环境等都是需要满足要求的。
国内试管平均成功率在50%左右
先怀孕,后付款-出生才是硬道理47岁1个卵泡一次成功经验分享不出国做三代-疫情下的试管新对策57岁供卵试管婴儿成功经验分享
助孕交流群
方法/步骤
随着试管婴儿技术的逐渐发展和成熟,现在越来越多的不孕患者选择通过这项辅助生殖技术来实现生育。很多患者为了进一步提高试管的成功率在胚胎移植前都会要求医生放2个胚胎,需要知道的是根据相关的规定来看,试管放2个胚胎是需要满足一定的条件的,并不是人人都适合的。
35岁以下身体素质好的女性才能够移植两枚胚胎
试管婴儿技术虽然是不孕患者生育的救命稻草,移植的成功率现在也在稳步上升,但是多胎妊娠的几率也在提高,增加了妊娠的风险。为了进一步降低试管多胎妊娠的几率,因此相关部门对于试管婴儿胚胎移植的数量做出了一定的规定和要求,目前已经不能够移植3个及以上的胚胎了,如果要放2个胚胎的话也是需要满足一定条件的,具体如下:
1、胚胎的数量
为了确保试管婴儿移植的成功率,因此对于患者的胚胎数量也是有要求的,患者至少需要两个及以上的可供移植的胚胎才可以,如果胚胎数量低于2个的话,那么就不能够在移植的时候放2个胚胎。
2、子宫环境
女性的子宫是胚胎着床和生长发育的重要场所,如果患者的宫腔环境存在异常的话,那么就会影响胚胎的着床,如果移植2个胚胎的话,即使成功着床了也会对女性的身体造成严重的伤害,因此只有子宫环境良好没有影响胚胎着床疾病的情况下才能够移植2枚。
3、女性年龄
相关部门的规定表示试管婴儿放2个胚胎的还需要结合女性的年龄进行判断,一般只有35岁以下身体素质比较好的女性才能够在试管移植的时候放2枚胚胎,以提高胚胎的着床率。
试管放2个胚胎的成活率
试管婴儿胚胎移植两个的存活率目前并没有明确的数据,因为每个患者的身体情况都是不同的,因此移植的成功率也是存在一定差异的。正常情况下移植两枚胚胎的成功率大概是在50%左右的,其实影响试管移植两枚胚胎成功率的因素有很多,大家可以详细了解一下。
胚胎的质量越高移植2个成功的存活率就越高
1年龄:如果女性的年龄比较大的话,那么移植2个胚胎的成功率也会下降,反之如果年龄比较小的话,成功率就会更高一些;2胚胎的质量:如果2个胚胎的质量都比较高的话,胚胎就会更加容易着床,如果胚胎的质量比较差属于三级胚胎,成活的几率就会比较低;2身体素质:移植前女性的子宫环境和身体各种激素如果都比较好都达标的话,成活必不会很难,但是如果存在异常的话,成功率就会受到影响。

发表评论